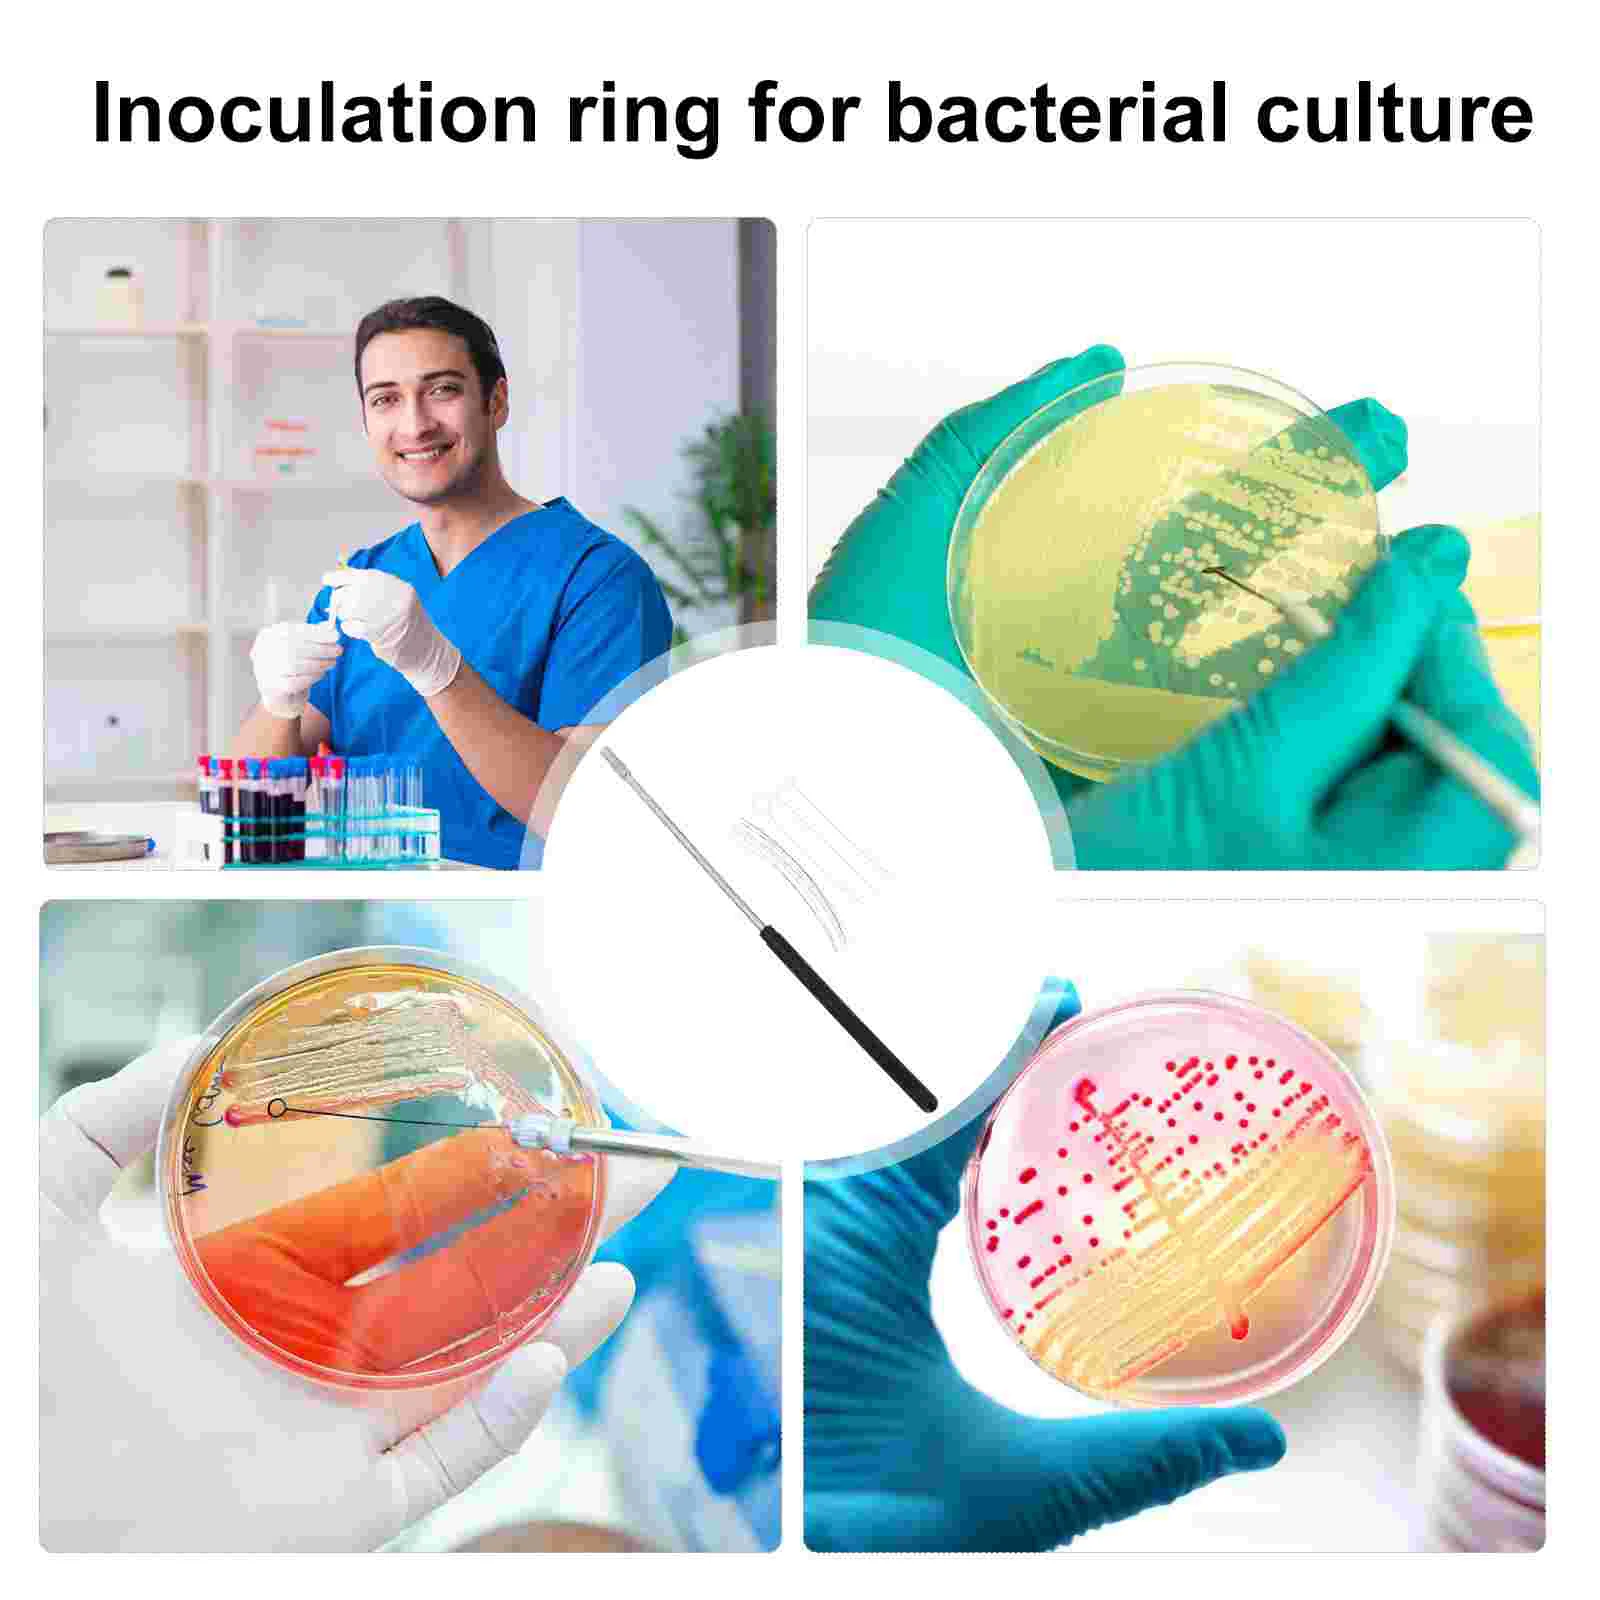

Лабораторная магнитная мешалка INTLLAB магнитный Миксер с мешальной стойкой 3000
6888
Новое поступление

Магазина Shop1103405360 Store работает с 18.12.2023. его рейтинг составлет 84.95 баллов из 100. В избранное добавили 21 покупателя. Средний рейтинг торваров продавца 4.4 в продаже представленно 13395 наименований товаров, успешно доставлено 132 заказов. 206 покупателей оставили отзывы о продавце.
Характеристики
*Текущая стоимость 428 уже могла изменится. Что бы узнать актуальную цену и проверить наличие товара, нажмите "Добавить в корзину"
| Месяц | Минимальная цена | Макс. стоимость | Цена |
|---|---|---|---|
| Sep-16-2025 | 509.93 руб. | 534.95 руб. | 521.5 руб. |
| Aug-16-2025 | 505.32 руб. | 530.21 руб. | 517.5 руб. |
| Jul-16-2025 | 424.20 руб. | 445.30 руб. | 434.5 руб. |
| Jun-16-2025 | 496.30 руб. | 521.48 руб. | 508.5 руб. |
| May-16-2025 | 432.14 руб. | 454.56 руб. | 443 руб. |
| Apr-16-2025 | 488.57 руб. | 512.82 руб. | 500 руб. |
| Mar-16-2025 | 484.83 руб. | 508.24 руб. | 496 руб. |
| Feb-16-2025 | 479.58 руб. | 503.38 руб. | 491 руб. |
| Jan-16-2025 | 475.76 руб. | 499.90 руб. | 487 руб. |
Описание товара

Смотрите так же другие товары: